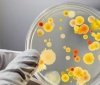
У Житомирі 13 дітей опинились в лікарні із харчовим отруєнням

В італійському готелі Rigapiano, який два дні тому накрила снігова лавина, знайшли шістьох вцілілих, передає УНН з посиланням на BBC.
За повідомленнями рятувальників, людей знайшли під снігом, проте ще не витягли.
Рятувальники просять просять дати їм на допомогу гелікоптери.
Також повідомляється, що щонайменше чотирьох людей знайшли мертвими, ще 20 вважаються зниклими.
Нагадаємо, лавина в Італії заблокувала готель з відвідувачами. На той момент у приміщенні перебували щонайменше 20 туристів і семеро працівників готелю.
Як повідомляв УНН, тіла трьох людей дістали із заваленого лавиною готелю.
Також нагадаємо, у МЗС України зазначили, що даних про українців у накритому сніговою лавиною готелі в Італії немає.
Джерело: УНН